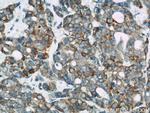
Calnexin Antibody in Immunohistochemistry (Paraffin) (IHC (P))
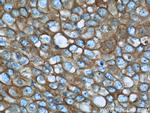
Calnexin Antibody in Immunohistochemistry (Paraffin) (IHC (P))

Search
Proteintech
Calnexin Polyclonal Antibody
{{$productOrderCtrl.translations['antibody.pdp.commerceCard.promotion.promotions']}}
{{$productOrderCtrl.translations['antibody.pdp.commerceCard.promotion.viewpromo']}}
{{$productOrderCtrl.translations['antibody.pdp.commerceCard.promotion.promocode']}}: {{promo.promoCode}} {{promo.promoTitle}} {{promo.promoDescription}}. {{$productOrderCtrl.translations['antibody.pdp.commerceCard.promotion.learnmore']}}
图: 1 / 17
Calnexin Antibody (10427-2-AP) in ICC/IF

Please note: We are reviewing Western blot images included in the antibody testing data in our catalog, including those provided by third parties. Unless expressly labeled or annotated as “raw-unedited”, Western blot images included in the antibody testing data in our catalog may have been edited, optimized or otherwise adjusted for presentation.
产品信息
10427-2-AP
种属反应
已发表种属
宿主/亚型
分类
类型
抗原
偶联物
形式
浓度
规格
纯化类型
保存液
内含物
保存条件
运输条件
产品详细信息
Immunogen sequence: MEGKWLLCM LLVLGTAIVE AHDGHDDDVI DIEDDLDDVI EEVEDSKPDT TAPPSSPKVT YKAPVPTGEV YFADSFDRGT LSGWILSKAK KDDTDDEIAK YDGKWEVEEM KESKLPGDKG LVLMSRAKHH AISAKLNKPF LFDTKPLIVQ YEVNFQNGIE CGGAYVKLLS KTPELNLDQF HDKTPYTIMF GPDKCGEDYK LHFIFRHKNP KTGIYEEKHA KRPDADLKTY FTDKKTHLYT LILNPDNSFE ILVDQSVVNS GNLLNDMTPP VNPS (1-273 aa encoded by BC003552)
靶标信息
Calnexin, also referred to as IP90, p88 and p90, is an approximately 90 kDa integral membrane protein of the endoplasmic reticulum (ER). Many resident ER proteins act as molecular chaperones and participate in the proper folding of polypeptides and their assembly into multisubunit proteins. Studies indicate that calnexin associates with the major histocompatibility complex (MHC) class I heavy chains, partial complexes of the T cell receptor and B cell membrane immunoglobulin, but not with completed receptor complexes. It has been shown that calnexin is a chaperone that retains incompletely or improperly folded proteins in the ER. The sequence Lys-Asp-Glu-Leu (KDEL) or a closely related sequence, is present at the carboxy-terminus of soluble ER resident proteins such as GRP78 and GRP94 and protein disulfide isomerase. Integral membrane ER resident proteins, like calnexin, often lack this KDEL sequence but contain positively charged cytosolic residues that ensure ER retention. Calnexin contains a large ER luminal domain (461 amino acids), a transmembrane segment (22 amino acids), and a cytoplasmic tail (89 amino acids).
仅用于科研。不用于诊断过程。未经明确授权不得转售。
生物信息学
蛋白别名: At5g07340; At5g61790; Calnexin; CANX; CNX; CNX1; CNX2; FLJ26570; IP90; MAC9.11; Major histocompatibility complex class I antigen-binding protein p88; p88; P90
基因别名: 1110069N15Rik; AI988026; CANX; Cnx; D11Ertd153e
UniProt ID: (Rat) P35565, (Mouse) P35564
Entrez Gene ID: (Rat) 29144, (Mouse) 12330




